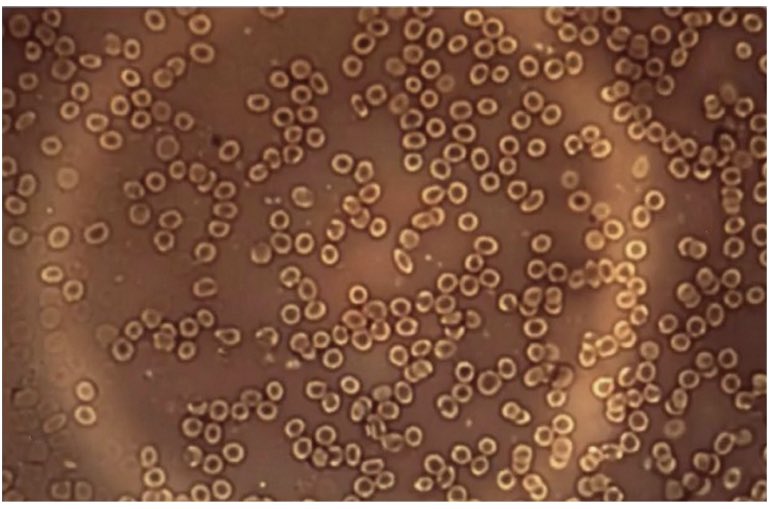

كذبوا عليك
على الرغم من التأكيدات المتكررة من السلطات ووسائل الإعلام الرئيسية بأن لقاحات Covid-19 آمنة وفعالة ، ظهرت أدلة مرارًا وتكرارًا تثبت أنهم لم يخبروا الحقيقة كاملة.
كان استخدام أكسيد الجرافين في لقاح Pfizer Covid-19 مصدرًا للجدل والقلق منذ البداية ، حيث ادعى العديد من…
على الرغم من التأكيدات المتكررة من السلطات ووسائل الإعلام الرئيسية بأن لقاحات Covid-19 آمنة وفعالة ، ظهرت أدلة مرارًا وتكرارًا تثبت أنهم لم يخبروا الحقيقة كاملة.
كان استخدام أكسيد الجرافين في لقاح Pfizer Covid-19 مصدرًا للجدل والقلق منذ البداية ، حيث ادعى العديد من…
جاري تحميل الاقتراحات...